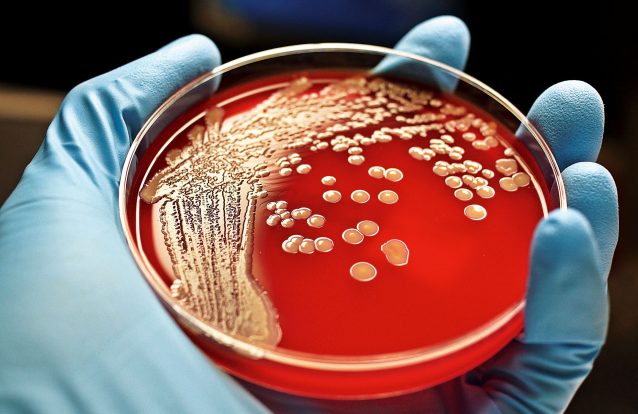
Antibióticos, 90 anos de história

Prémio Nobel da Medicina
Nobel da Física atribuído a cientistas por usarem laser para estudar eletrões
O prémio Nobel da Física foi atribuído a Pierre Agostini, Ferenc Kraus e Anne L'Huillier por observarem eletrões nos átomos na mais pequena fração de segundo, anunciou hoje a Real Academia Sueca de Ciências
Doenças genéticas, medicina regenerativa ou autoimunes poderão ser áreas de aplicação da tecnologia RNA, explica professor do Técnico
Depois de ter salvado milhões de vidas, com a vacina contra a Covid, o Comité Nobel vem reforçar o enorme potencial da tecnologia de RNA mensageiro, atribuindo o Nobel da Medicina e Fisiologia aos cientistas que a desenvolveram. Miguel Prazeres trabalha na otimização do processo de produção, para que a tecnologia chegue a mais pessoas e trate mais doenças
Nobel da Medicina atribuído a descobertas que levaram à vacina da covid-19
O prémio Nobel da Medicina foi atribuído a Katalin Karikó e a Drew Weissman por descobertas que permitiram o desenvolvimento de vacinas mRNA eficazes contra a covid-19, anunciou hoje a academia
Como percebemos o calor e o frio? Nobel da Medicina atribuído a cientistas que descobriram recetores da temperatura e do toque
O prémio Nobel da Medicina foi atribuído conjuntamente a David Julius e Ardem Patapoutian pelo seu trabalho na descoberta dos recetores da temperatura e do toque - sec-geral do Comité Nobel
Comentários racistas valem perda de títulos honoríficos a Prémio Nobel da Medicina
O laboratório que James Watson, prémio Nobel da Medicina em 1962, dirigiu considera que as suas opiniões sobre as diferenças de inteligência entre raças são "repreensíveis", além de "injustificáveis pela ciência"
Antibióticos, 90 anos de história
Há precisamente 90 anos, Alexander Fleming descobriu a penicilina. E as infeções, anteriormente fatais, passaram a ser curáveis. Mas nove décadas depois há novos riscos à espreita
Nobel da Medicina para três investigadores que decifram o relógio interno do organismo
O Prémio Nobel da Medicina deste ano vai ser entregue a três investigadores que descobriram como funciona o relógio interno do organismo e quais os genes que o influenciam.
Nobel da Medicina distingue descoberta sobre relógio biológico
O prémio Nobel da Medicina foi hoje atribuído em conjunto aos investigadores Jeferry C. Hall, Miichael Rosbash e Michael W. Young por descobertas relativas ao mecanismos moleculares que controlam o ritmo circadiano
Liberdade e livre arbítrio na neurociência: a ciência também censura
Ainda bem que “Mein Kampf” voltou a ser editado e distribuído. A sua leitura crítica, que a maioria dos leitores fará, certamente permitirá consolidar a ideia da liberdade como projecto humano